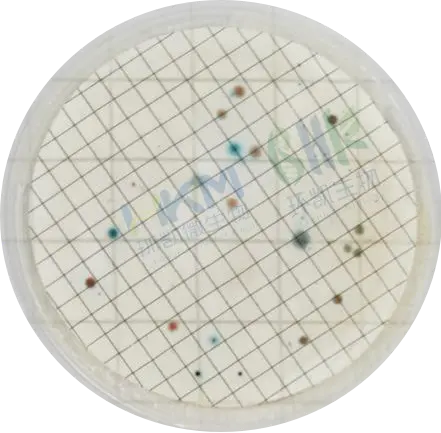
滤膜法培养24±2h后 滤膜法培养24±2h后
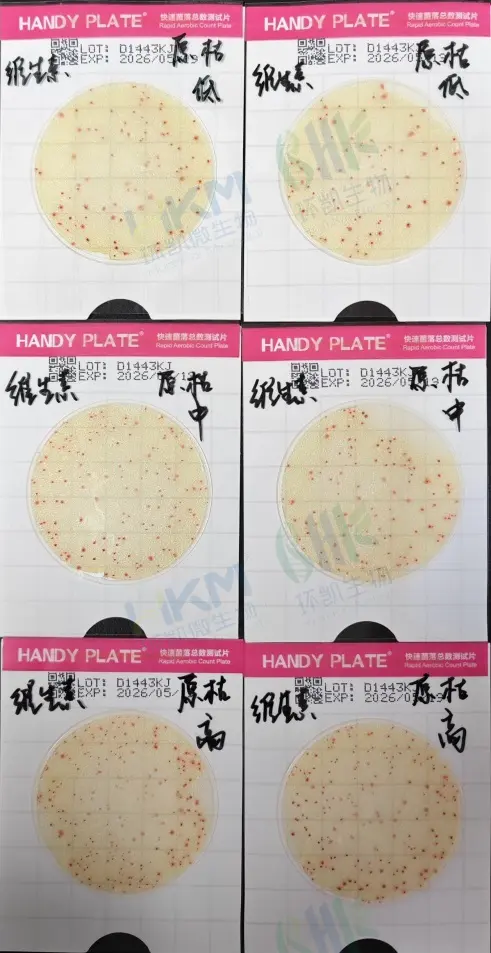
测试片 — 枯草芽孢杆菌ATCC6633 测试片 — 枯草芽孢杆菌ATCC6633
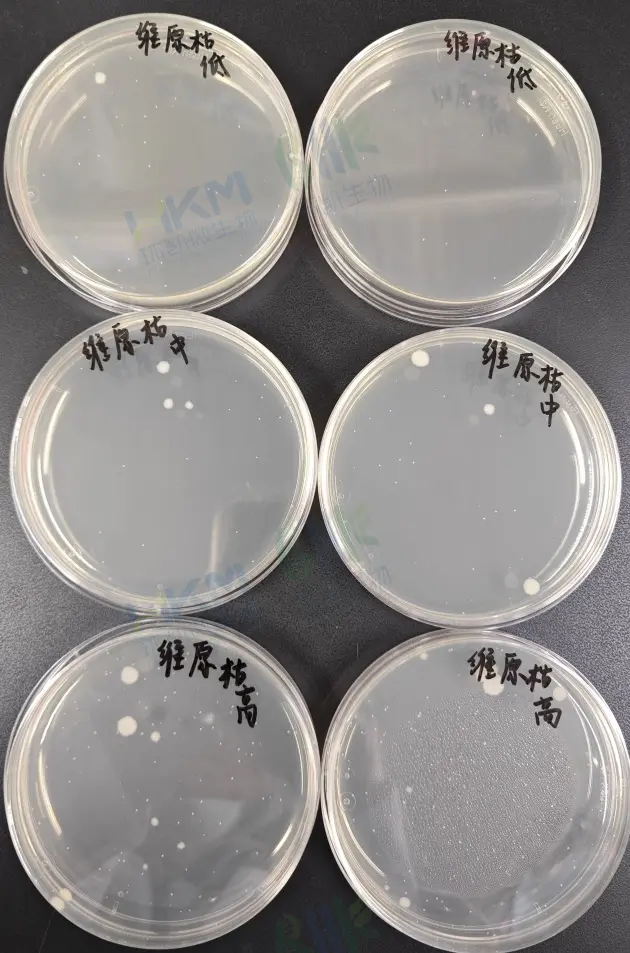
PCA — 枯草芽孢杆菌ATCC6633 PCA — 枯草芽孢杆菌ATCC6633

环凯HandyPlate®测试片在饮料行业的应用
发布时间:2025-04-02 浏览次数:618 分享:
HandyPlate®快速菌落总数测试片强势来袭,为饮料菌落总数检验量身定做。
![]() | ![]() |
| 快速菌落总数测试片(滤膜法) | 快速菌落总数测试片(缓冲体系) |
一、快速菌落总数测试片原理
测试片主要营养成分与平板计数琼脂培养基配方一致,结合冷水凝胶和特异性的的复合酶底物显色剂制成,在36℃±1℃培养24±2h,微生物生长代谢产生的酶水解菌落分解显色剂,不同类型的菌落在测试片上会显示出红色、蓝绿色或蓝红色等不同的颜色标识,从而实现对微生物的有效鉴别和计数。
二、HandyPlate®快速菌落总数测试片检验饮料的优势
1、防止漏检:当饮料含菌量极低时,加1mL样液可能造成假阴性。对此,环凯生物开发专用的快速菌落总数测试片滤膜法,来检验饮料。允许至少10ml饮料量进行过滤处理,有效将微生物截留在滤膜上,再将其贴于测试片上培养,实现滤膜法检验,杜绝假阴性。
2、菌落易于观察:滤膜法快速菌落总数测试片采用有独特的透明底片设计,使得经过滤膜加入并培养后菌落更加容易观察计数,解决了传统法菌落在滤膜上生长颜色和滤膜本身颜色难以区分的问题。
3、中和饮料pH高低问题 :测试片含缓冲体系,可以有效中和饮料的酸碱度,从而解决因pH不适导致的微生物生长受抑制的问题。
4、操作简便高效:无需配制培养基、灭菌等步骤,避免了使用传统琼脂培养基对微生物造成的热损伤,且24±2h即可生长显色,大大提高了工作效率。
三、快速菌落总数测试片(滤膜法)检验饮料
根据饮料污染情况的初步估计,选择1〜2个适宜稀释度的样品匀液(液体样品可为原液)进行抽滤检验,每份样品的过滤量不少于10mL。使用无菌夹夹取滤膜放置于已灭菌滤床上,注意格栅面朝上,安装固定好滤杯进行抽滤操作。
当全部样品匀液过滤后,在滤杯中加不少于15mL无菌生理盐水中进行抽滤冲洗。全部液体通过滤膜后,小心取下滤杯,并将滤膜取出;轻轻掀开测试片上膜(在此之前用1mL生理盐水润湿测试片2min 左右,但请注意润湿时间过长则容易粘膜),将滤膜格栅面朝下放置于测试片上,重新盖上测试片上膜,用手轻轻按压排除气泡。
将测试片正面向上水平放置,在36℃±1℃,培养24h±2h培养,若有必要可适当延长培养时间。观察时,将测试片正面翻转,通过背面计数所有颜色菌落(蓝绿、蓝红、红色等)不论大小和清晰度,均应计入总数。
![]() | ![]() |
| 滤膜法培养前 | 滤膜法培养24±2h后 |
四、快速菌落总数测试片(缓冲体系)检验饮料
使用时,可直接取1mL的饮料原液加入测试片中进行检测,若饮料含菌量过高,可进行适当稀释再接种至测试片中。测试片在36℃±1℃培养24±2h后观察结果。
例如检验的某品牌饮料,其pH测得3.81,将饮料原液分别和金黄色葡萄球菌ATCC6538、枯草芽孢杆菌ATCC6633混合进行检验,结果显示其性能良好,检验结果与PCA 48h结果无明显差异。这表明该快速菌落总数测试片在处理pH值极端的饮料样品时具有可靠性和准确性。
结果示例图:
![]() | ![]() |
| 金黄色葡萄球菌ATCC6538 | |
![]() | ![]() |
| 枯草芽孢杆菌ATCC6633 | |
总之,我们针对不同类型饮料的菌落总数检验提供定制化的解决方案,精准高效解决饮料菌落总数检验问题,Handy Plate ®快速菌落总数测试片专为满足多样化的饮料检验需求而设计,无论是酸性或碱性饮料、果汁还是茶饮等,都能够精准高效地完成微生物检测任务。,我们的产品旨在提供便捷、可靠的检测手段,助力企业保障产品质量与安全。如有任何需求或疑问,欢迎随时咨询获取更多详情和支持。